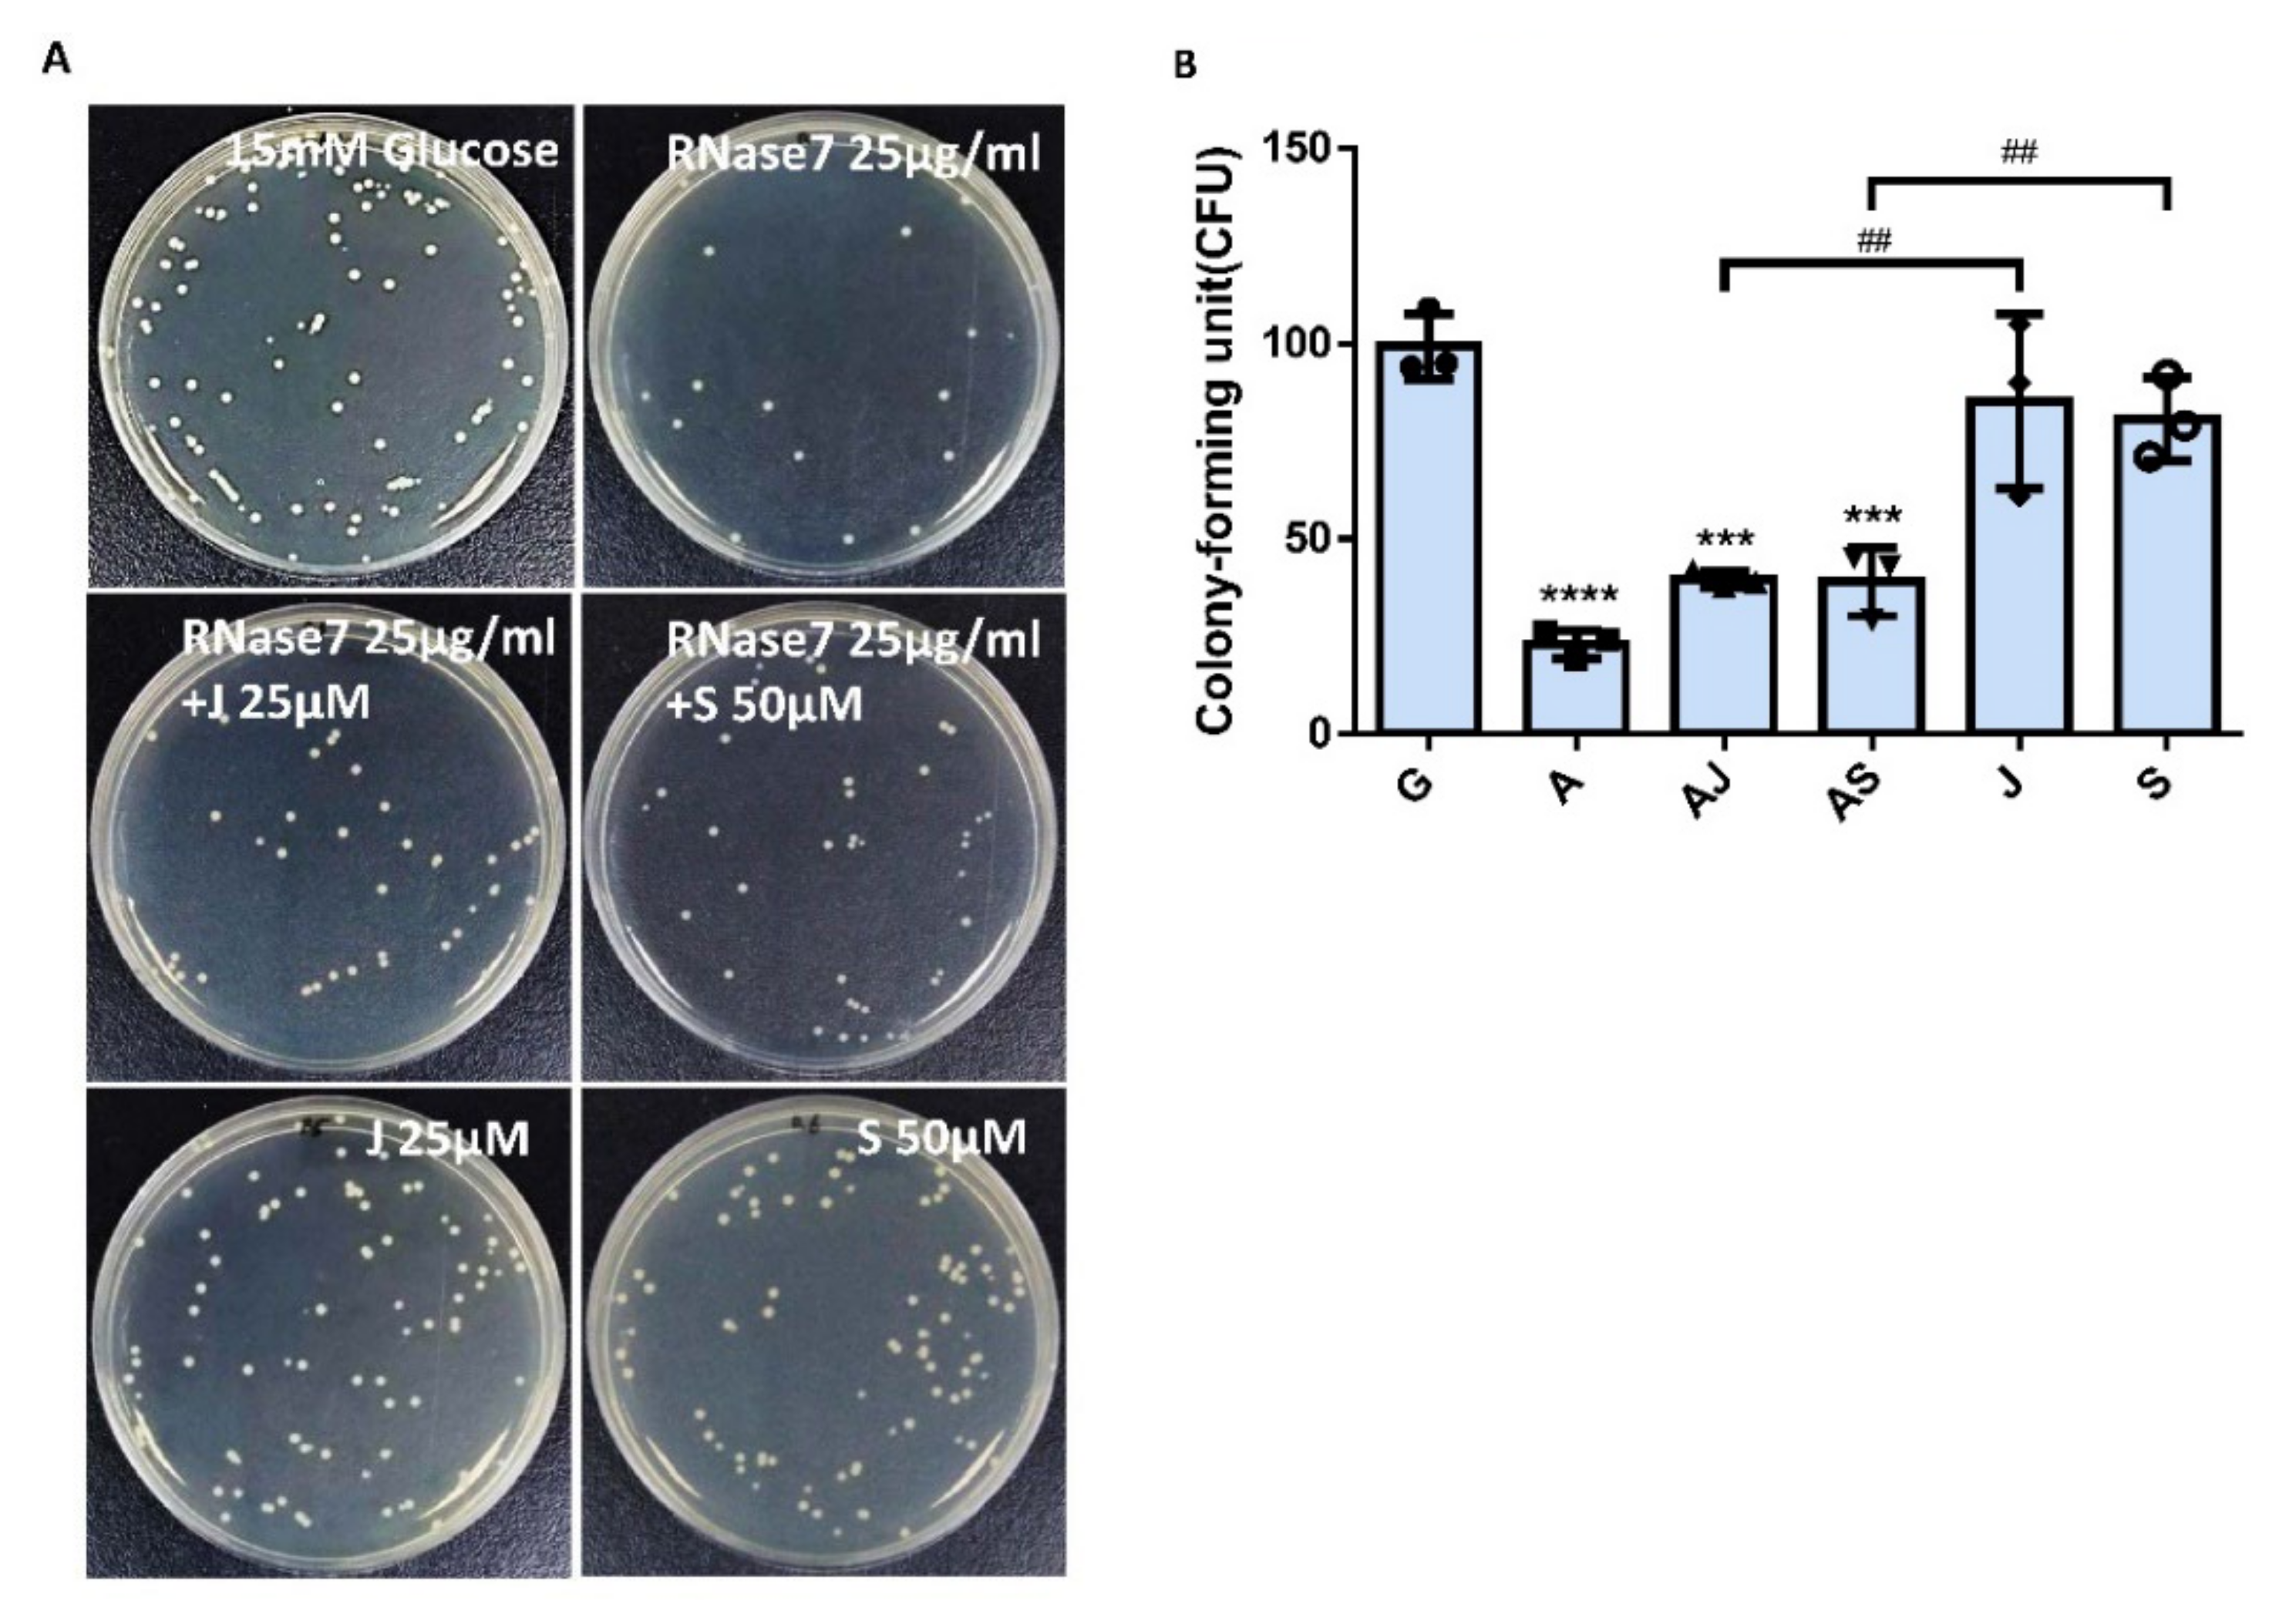
Ijms 23 05156 g007

RNase 7 Inhibits Uropathogenic Escherichia coli-Induced Inflammation in Bladder Cells under a High-Glucose Environment by Regulating the JAK/STAT Signaling Pathway
Abstract
:1. Introduction
2. Results
2.1. RNase 7 Suppressed the Glucose-Enhanced UPEC Infection in Bladder Epithelial Cells
2.2. Decrease in UPEC Infection in Bladder Epithelial Cells by RNase 7 Was Related to Downregulation of STAT1, STAT3, and TLR4 Expression
2.3. RNase 7 Decreased UPEC Infection-Induced Exogenous Inflammatory Cytokine Secretion
2.4. RNase 7 Suppressed the Enhanced Expression of TLR4 and JAK/STAT Signaling Pathway in Bladder Cells with UPEC Infection in a Concentration-Dependent Manner
2.5. RNase 7 Decreased the UPEC Infection in Bladder Epithelial Cells through Regulation of the JAK/STAT1 Signaling Pathway
2.6. Increased UPEC Infection in Bladder Epithelial Cells in a High-Glucose Environment Was Inhibited by RNase 7 Downregulating the JAK/STAT Pathway-Related Proteins
3. Discussion
4. Materials and Methods
4.1. Cell Culture
4.2. Bacterial Strain
4.3. RNase 7 Treatments
4.4. UPEC Infections and Quantifying
4.5. Cytometric Bead Array Immunoassay
4.6. Cell Protein Extraction
4.7. Western Blotting
4.8. Statistical Analysis
5. Conclusions
Supplementary Materials
Author Contributions
Funding
Institutional Review Board Statement
Informed Consent Statement
Data Availability Statement
Conflicts of Interest
References
- Goldstein, I.; Dicks, B.; Kim, N.N.; Hartzell, R. Multidisciplinary overview of vaginal atrophy and associated genitourinary symptoms in postmenopausal women. Sex. Med. 2013, 1, 44–53. [Google Scholar] [CrossRef] [PubMed] [Green Version]
- Dielubanza, E.J.; Schaeffer, A.J. Urinary tract infections in women. Med. Clin. 2011, 95, 27–41. [Google Scholar] [CrossRef] [PubMed]
- Ailes, E.C.; Gilboa, S.M.; Gill, S.K.; Broussard, C.S.; Crider, K.S.; Berry, R.J.; Carter, T.C.; Hobbs, C.A.; Interrante, J.D.; Reefhuis, J.; et al. Association between antibiotic use among pregnant women with urinary tract infections in the first trimester and birth defects, National Birth Defects Prevention Study 1997 to 2011. Birth Defects Res. A Clin. Mol. Teratol. 2016, 106, 940–949. [Google Scholar] [CrossRef] [Green Version]
- Ali, A.S.; Townes, C.L.; Hall, J.; Pickard, R.S. Maintaining a sterile urinary tract: The role of antimicrobial peptides. J. Urol. 2009, 182, 21–28. [Google Scholar] [CrossRef] [PubMed]
- Tseng, C.C.; Wu, J.J.; Wang, M.C.; Hor, L.I.; Ko, Y.H.; Huang, J.J. Host and bacterial virulence factors predisposing to emphysematous pyelonephritis. Am. J. Kidney Dis. 2005, 46, 432–439. [Google Scholar] [CrossRef] [PubMed]
- Zasloff, M. Antimicrobial peptides, innate immunity, and the normally sterile urinary tract. J. Am. Soc. Nephrol. 2007, 18, 2810–2816. [Google Scholar] [CrossRef] [PubMed] [Green Version]
- Almeida, P.F.; Pokorny, A. Mechanisms of antimicrobial, cytolytic, and cell-penetrating peptides: From kinetics to thermodynamics. Biochemistry 2009, 48, 8083–8093. [Google Scholar] [CrossRef] [Green Version]
- Splith, K.; Neundorf, I. Antimicrobial peptides with cell-penetrating peptide properties and vice versa. Eur. Biophys. J. 2011, 40, 387–397. [Google Scholar] [CrossRef]
- Yeaman, M.R.; Yount, N.Y. Mechanisms of antimicrobial peptide action and resistance. Pharmacol. Rev. 2003, 55, 27–55. [Google Scholar] [CrossRef] [Green Version]
- Harder, J.; Schröder, J.-M. RNase 7, a novel innate immune defense antimicrobial protein of healthy human skin. J. Biol. Chem. 2002, 277, 46779–46784. [Google Scholar] [CrossRef] [Green Version]
- Spencer, J.D.; Schwaderer, A.L.; Wang, H.; Bartz, J.; Kline, J.; Eichler, T.; DeSouza, K.R.; Sims-Lucas, S.; Baker, P.; Hains, D.S. Ribonuclease 7, an antimicrobial peptide upregulated during infection, contributes to microbial defense of the human urinary tract. Kidney Int. 2013, 83, 615–625. [Google Scholar] [CrossRef] [PubMed] [Green Version]
- Tandogdu, Z.; Cai, T.; Koves, B.; Wagenlehner, F.; Bjerklund-Johansen, T.E. Urinary Tract Infections in Immunocompromised Patients with Diabetes, Chronic Kidney Disease, and Kidney Transplant. Eur. Urol. Focus 2016, 2, 394–399. [Google Scholar] [CrossRef] [PubMed]
- Kobayashi, M.; Uematsu, T.; Nakamura, G.; Kokubun, H.; Mizuno, T.; Betsunoh, H.; Kamai, T. The Predictive Value of Glycated Hemoglobin and Albumin for the Clinical Course Following Hospitalization of Patients with Febrile Urinary Tract Infection. Infect. Chemother. 2018, 50, 228–237. [Google Scholar] [CrossRef] [PubMed]
- Meguro, S.; Tomita, M.; Katsuki, T.; Kato, K.; Oh, H.; Ainai, A.; Ito, R.; Kawai, T.; Itoh, H.; Hasegawa, H. Plasma Antimicrobial Peptide LL-37 Level Is Inversely Associated with HDL Cholesterol Level in Patients with Type 2 Diabetes Mellitus. Int. J. Endocrinol. 2014, 2014, 703696. [Google Scholar] [CrossRef]
- Rodriguez-Carlos, A.; Trujillo, V.; Gonzalez-Curiel, I.; Marin-Luevano, S.; Torres-Juarez, F.; Santos-Mena, A.; Rivas-Santiago, C.; Enciso-Moreno, J.A.; Zaga-Clavellina, V.; Rivas-Santiago, B. Host Defense Peptide RNase 7 Is Down-regulated in the Skin of Diabetic Patients with or without Chronic Ulcers, and its Expression is Altered with Metformin. Arch. Med. Res. 2020, 51, 327–335. [Google Scholar] [CrossRef]
- Eichler, T.E.; Becknell, B.; Easterling, R.S.; Ingraham, S.E.; Cohen, D.M.; Schwaderer, A.L.; Hains, D.S.; Li, B.; Cohen, A.; Metheny, J.; et al. Insulin and the phosphatidylinositol 3-kinase signaling pathway regulate Ribonuclease 7 expression in the human urinary tract. Kidney Int. 2016, 90, 568–579. [Google Scholar] [CrossRef] [Green Version]
- Ho, C.H.; Fan, C.K.; Wu, C.C.; Yu, H.J.; Liu, H.T.; Chen, K.C.; Liu, S.P.; Cheng, P.C. Enhanced uropathogenic Escherichia coli-induced infection in uroepithelial cells by sugar through TLR-4 and JAK/STAT1 signaling pathways. J. Microbiol. Immunol. Infect. 2021, 54, 193–205. [Google Scholar] [CrossRef]
- Ho, C.H.; Fan, C.K.; Yu, H.J.; Wu, C.C.; Chen, K.C.; Liu, S.P.; Cheng, P.C. Testosterone suppresses uropathogenic Escherichia coli invasion and colonization within prostate cells and inhibits inflammatory responses through JAK/STAT-1 signaling pathway. PLoS ONE 2017, 12, e0180244. [Google Scholar] [CrossRef] [Green Version]
- Mashili, F.; Chibalin, A.V.; Krook, A.; Zierath, J.R.J.D. Constitutive STAT3 phosphorylation contributes to skeletal muscle insulin resistance in type 2 diabetes. Diabetes 2013, 62, 457–465. [Google Scholar] [CrossRef] [Green Version]
- Kim, T.H.; Choi, S.E.; Ha, E.S.; Jung, J.G.; Han, S.J.; Kim, H.J.; Kim, D.J.; Kang, Y.; Lee, K.W.J.A.d. IL-6 induction of TLR-4 gene expression via STAT3 has an effect on insulin resistance in human skeletal muscle. Acta Diabetol. 2013, 50, 189–200. [Google Scholar] [CrossRef]
- Ho, C.H.; Liu, S.P.; Fan, C.K.; Tzou, K.Y.; Wu, C.C.; Cheng, P.C. Insulin Downregulated the Infection of Uropathogenic Escherichia coli (UPEC) in Bladder Cells in a High-Glucose Environment through JAK/STAT Signaling Pathway. Microorganisms 2021, 9, 2421. [Google Scholar] [CrossRef] [PubMed]
- Weichhart, T.; Haidinger, M.; Horl, W.H.; Saemann, M.D. Current concepts of molecular defence mechanisms operative during urinary tract infection. Eur. J. Clin. Investig. 2008, 38 (Suppl. 2), 29–38. [Google Scholar] [CrossRef] [PubMed]
- Abraham, S.N.; Miao, Y. The nature of immune responses to urinary tract infections. Nat. Rev. Immunol. 2015, 15, 655–663. [Google Scholar] [CrossRef] [PubMed] [Green Version]
- Song, J.; Abraham, S.N. Tlr-Mediated Immune Responses in the Urinary Tract. Curr. Opin. Microbiol. 2008, 11, 66–73. [Google Scholar] [CrossRef] [Green Version]
- Ho, C.-H.; Lu, Y.-C.; Fan, C.-K.; Yu, H.-J.; Liu, H.-T.; Wu, C.-C.; Chen, K.-C.; Liu, S.-P.; Cheng., P.-C. Testosterone Regulates the Intracellular Bacterial Community Formation of Uropathogenic Escherichia Coli in Prostate Cells Via Stat3. Int. J. Med. Microbiol. 2020, 310, 151450. [Google Scholar] [CrossRef]
- Amatngalim, G.D.; van Wijck, Y.; de Mooij-Eijk, Y.; Verhoosel, R.M.; Harder, J.; Lekkerkerker, A.N.; Janssen, R.A.; Hiemstra, P.S. Basal cells contribute to innate immunity of the airway epithelium through production of the antimicrobial protein RNase 7. J. Immunol. 2015, 194, 3340–3350. [Google Scholar] [CrossRef] [Green Version]
- Simanski, M.; Rademacher, F.; Schroder, L.; Schumacher, H.M.; Glaser, R.; Harder, J. IL-17A and IFN-gamma synergistically induce RNase 7 expression via STAT3 in primary keratinocytes. PLoS ONE 2013, 8, e59531. [Google Scholar] [CrossRef] [Green Version]
- Pierce, K.R.; Eichler, T.; Mosquera Vasquez, C.; Schwaderer, A.L.; Simoni, A.; Creacy, S.; Hains, D.S.; Spencer, J.D. Ribonuclease 7 polymorphism rs1263872 reduces antimicrobial activity and associates with pediatric urinary tract infections. J. Clin. Investig. 2021, 131, e149807. [Google Scholar] [CrossRef]
- Entezari, M.; Weiss, D.J.; Sitapara, R.; Whittaker, L.; Wargo, M.J.; Li, J.; Wang, H.; Yang, H.; Sharma, L.; Phan, B.D.; et al. Inhibition of high-mobility group box 1 protein (HMGB1) enhances bacterial clearance and protects against Pseudomonas Aeruginosa pneumonia in cystic fibrosis. Mol. Med. 2012, 18, 477–485. [Google Scholar] [CrossRef]
- Lu, B.; Antoine, D.J.; Kwan, K.; Lundback, P.; Wahamaa, H.; Schierbeck, H.; Robinson, M.; Van Zoelen, M.A.; Yang, H.; Li, J.; et al. JAK/STAT1 signaling promotes HMGB1 hyperacetylation and nuclear translocation. Proc. Natl. Acad. Sci. USA 2014, 111, 3068–3073. [Google Scholar] [CrossRef] [Green Version]
- Tang, D.; Kang, R.; Livesey, K.M.; Cheh, C.W.; Farkas, A.; Loughran, P.; Hoppe, G.; Bianchi, M.E.; Tracey, K.J.; Zeh, H.J., 3rd; et al. Endogenous HMGB1 regulates autophagy. J. Cell Biol. 2010, 190, 881–892. [Google Scholar] [CrossRef]
- Berry, R.E.; Klumpp, D.J.; Schaeffer, A.J. Urothelial cultures support intracellular bacterial community formation by uropathogenic Escherichia coli. Infect. Immun. 2009, 77, 2762–2772. [Google Scholar] [CrossRef] [PubMed] [Green Version]
- Baune, B.T.; Ponath, G.; Golledge, J.; Varga, G.; Arolt, V.; Rothermundt, M.; Berger, K. Association between IL-8 cytokine and cognitive performance in an elderly general population—The MEMO-Study. Neurobiol. Aging 2008, 29, 937–944. [Google Scholar] [CrossRef] [PubMed]
- Dhabhar, F.S.; Viswanathan, K. Short-term stress experienced at time of immunization induces a long-lasting increase in immunologic memory. Am. J. Physiol. Regul. Integr. Comp. Physiol. 2005, 289, R738–R744. [Google Scholar] [CrossRef] [PubMed]

Publisher’s Note: MDPI stays neutral with regard to jurisdictional claims in published maps and institutional affiliations. |
© 2022 by the authors. Licensee MDPI, Basel, Switzerland. This article is an open access article distributed under the terms and conditions of the Creative Commons Attribution (CC BY) license (https://creativecommons.org/licenses/by/4.0/).
Share and Cite
Ho, C.-H.; Liao, P.-W.; Fan, C.-K.; Liu, S.-P.; Cheng, P.-C. RNase 7 Inhibits Uropathogenic Escherichia coli-Induced Inflammation in Bladder Cells under a High-Glucose Environment by Regulating the JAK/STAT Signaling Pathway. Int. J. Mol. Sci. 2022, 23, 5156. https://doi.org/10.3390/ijms23095156
Ho C-H, Liao P-W, Fan C-K, Liu S-P, Cheng P-C. RNase 7 Inhibits Uropathogenic Escherichia coli-Induced Inflammation in Bladder Cells under a High-Glucose Environment by Regulating the JAK/STAT Signaling Pathway. International Journal of Molecular Sciences. 2022; 23(9):5156. https://doi.org/10.3390/ijms23095156
Chicago/Turabian StyleHo, Chen-Hsun, Pin-Wen Liao, Chia-Kwung Fan, Shih-Ping Liu, and Po-Ching Cheng. 2022. "RNase 7 Inhibits Uropathogenic Escherichia coli-Induced Inflammation in Bladder Cells under a High-Glucose Environment by Regulating the JAK/STAT Signaling Pathway" International Journal of Molecular Sciences 23, no. 9: 5156. https://doi.org/10.3390/ijms23095156
APA StyleHo, C.-H., Liao, P.-W., Fan, C.-K., Liu, S.-P., & Cheng, P.-C. (2022). RNase 7 Inhibits Uropathogenic Escherichia coli-Induced Inflammation in Bladder Cells under a High-Glucose Environment by Regulating the JAK/STAT Signaling Pathway. International Journal of Molecular Sciences, 23(9), 5156. https://doi.org/10.3390/ijms23095156

